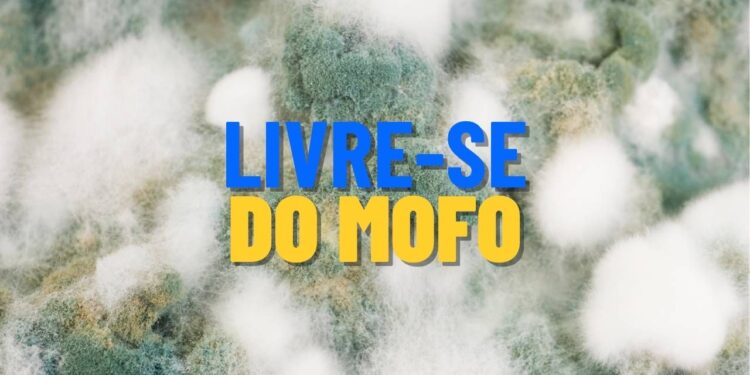
Truques aprovados para eliminar mofo e umidade de vez

Ambientes úmidos favorecem o surgimento de mofo e odores desagradáveis, que comprometem tanto a estética quanto a saúde dentro de casa.
Felizmente, empresas especializadas já testaram soluções simples, eficazes e acessíveis para lidar com esse problema de forma definitiva.
Por que o mofo e o cheiro de umidade continuam voltando mesmo após a limpeza?
Mesmo após uma boa faxina, o mofo tende a retornar se a raiz do problema não for resolvida: a umidade excessiva no ambiente. Isso inclui falta de ventilação, infiltrações ou uso de produtos inadequados.
Outro erro comum é aplicar desinfetantes perfumados que mascaram o cheiro sem remover a causa. A solução exige abordagem dupla: remover o fungo e controlar a umidade.
💧 Causas e Soluções para Umidade em Casa
Principais causas, consequências e soluções práticas.
| Causa da umidade | Consequência | Solução recomendada |
|---|---|---|
| Falta de ventilação | Ambiente abafado favorece fungos | Abrir janelas, instalar exaustores ou ventiladores |
| Infiltração em paredes | Manchas, descascamento e mofo | Verificar e reparar vazamentos com impermeabilização |
| Roupas úmidas em armários | Cheiro de mofo em roupas e sapatos | Só guardar itens completamente secos |
| Má vedação de janelas | Entrada de água da chuva e aumento da umidade | Reforçar a vedação com silicone ou fitas adesivas |
| Uso de produtos inadequados | Máscara o cheiro mas não combate o mofo | Usar vinagre, bicarbonato, álcool ou antifúngicos naturais |
Lavanderia bem ventilada reduz focos de umidade invisíveis
Pequenos ajustes na lavanderia podem evitar a formação de mofo nos cantos e atrás dos móveis.
- Instale um exaustor ou deixe janelas abertas após o uso da máquina
- Evite roupas molhadas acumuladas em cestos fechados
- Use bicarbonato nas frestas do piso e atrás da lavadora
Esse espaço costuma ser negligenciado, mas com ações simples, é possível controlar a umidade constante e os odores que ela gera.
Guarda-roupa arejado previne mofo nas roupas e sapatos
Os armários acumulam umidade vinda das paredes externas e da condensação em dias frios, criando ambiente ideal para fungos.
- Use desumidificadores naturais como carvão ativado ou giz
- Deixe as portas abertas por algumas horas semanalmente
- Limpe o interior com vinagre branco a cada 15 dias
Roupas guardadas úmidas também contribuem para o cheiro de mofo, por isso é essencial garantir que tudo esteja bem seco antes de guardar.
Cozinha ventilada garante ambientes secos e sem cheiro de bolor
O vapor da cozinha, se mal direcionado, contribui para mofo nas paredes, nos armários e até nas cortinas.
- Use coifa ou exaustor durante o preparo de alimentos
- Limpe azulejos com solução de vinagre e álcool
- Evite tapetes e cortinas grossas que retêm umidade
Além da limpeza, é essencial manter o ar circulando, especialmente em cantos menos visíveis como embaixo da pia e atrás do fogão.

Como manter a casa protegida de forma contínua e econômica?
Adotar pequenos hábitos semanais pode evitar o retorno do mofo e dos maus odores.
- Limpeza periódica com produtos antifúngicos naturais
- Uso de cal virgem ou giz em cantos propensos à umidade
- Verificação frequente de infiltrações e goteiras
Esses cuidados garantem que o ambiente continue saudável e com cheiro neutro, sem depender de produtos químicos agressivos.
Eliminar mofo e cheiro de umidade exige mais do que produtos potentes: é uma questão de manter o ambiente equilibrado e seco ao longo do tempo.